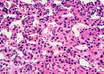

Pathway contributing to fatty liver disease discovered
MedicalXpress Breaking News-and-Events | Apr 14, 2019
A new molecule to fight type 2 diabetes and non-alcoholic fatty liver disease
ScienceDaily | Apr 13, 2019
The protein p38-gamma identified as a new therapeutic target in liver cancer
MedicalXpress Breaking News-and-Events | Apr 13, 2019
Movement toward a poop test for liver cirrhosis
Newswise | Apr 02, 2019
Researchers identify potential new therapy for liver diseases
MedicalXpress Breaking News-and-Events | Mar 27, 2019
Preclinical data shows combination immunotherapy could stop liver cancer growth
MedicalXpress Breaking News-and-Events | Mar 17, 2019
First genetic clue for elusive pediatric liver disease
MedicalXpress Breaking News-and-Events | Mar 07, 2019
Toward a blood test for early stage liver disease
MedicalXpress Breaking News-and-Events | Mar 05, 2019